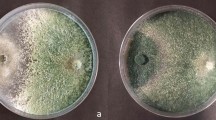

Abstract
Actinobacteria have been drawing attention due to their potential for the development of new pest control products. We hereby assess the effects of Streptomyces isolated from marine and caatinga biomes against Duponchelia fovealis Zeller (Lepidoptera: Crambidae), a pest associated with the strawberry culture at a global scale. To this end, eggs deposited by adults were immersed for 5 s in a bacterial suspension, and the larvae were fed on leaflets placed in glass tubes containing bacterial suspensions. In both treatments, the control was a saline solution. The bioassays demonstrated that the Streptomyces strains were able to cause the death of D. fovealis eggs (≈ 40%) and larvae (≈ 65%) compared to untreated eggs (1.4%) and larvae (2.0%). The crude extract of strain T49 and the chitinase extract of strain T26 affected larval growth when applied directly to the thorax of first-instar larvae (larval-adult lifespan of 65.3 ± 0.5 days and 67.5 ± 0.7 days, respectively; survival of 61.2 ± 1.2%) in relation to the control treatment (larval-adult lifespan of 41.75 ± 0.2 days and survival of 83.7 ± 2.6%). The Streptomyces spp. strains T41, T49, and T50 caused antifeeding activity. Apart from larval mortality, the adults that emerged from the larvae exposed to the extracts presented morphological abnormalities, and the moths’ chitin spectra showed clear alterations to the pupa and wings. Our studies show, for the very first time, that Streptomyces isolated from the marine environment and the Caatinga biome are effective at provoking the mortality of D. fovealis and are promising agents for developing new products with biological control properties.
Similar content being viewed by others
Explore related subjects
Discover the latest articles, news and stories from top researchers in related subjects.Avoid common mistakes on your manuscript.
Introduction
The European pepper moth Duponchelia fovealis (Zeller) (Lepidoptera: Crambidae) is native to the freshwater and saltwater marshes of southern Europe and the eastern Mediterranean region (Stocks and Hodges 2011). It is a polyphagous pest that infects important food crops and ornamental species, such as pepper, maize, and begonias worldwide (Brambila and Stocks 2010; Zawadneak et al. 2017), thus causing great economic loss. Since 2010 there have been multiple reports of D. fovealis attacking strawberry plants (Fragaria × ananassa Duchesne) in different world regions (Zawadneak et al. 2016).
Duponchelia fovealis larvae feed on leaves, flowers, and fruits (Zawadneak et al. 2016). Larvae are difficult to detect due to their habit of hiding in sheltered places, such as inside stems, fruits, under leaves and soil debris, and under or in plant pots (Brambila and Stocks 2010). These habits also decrease the efficacy of certain pesticides, and the absence of adequate control methods might lead to serious negative economic implications (Zawadneak et al. 2016). Nevertheless, biological control can be employed in the management of D. fovealis to minimize the impact of this pest on crops (Matyjaszcyk 2015; Moshi and Matoju 2017).
That being the case, the use of microorganisms is a promising alternative in the biological control of D. fovealis in strawberry fields (Harper 2006; Zawadneak et al. 2016; Amatuzzi et al. 2017, 2018). The insect is contaminated by the biopesticide when it gets in touch with sprayed surfaces. In addition to eliciting epizootics that regulate the pest population, the use of biopesticides offers other advantages such as reduced environmental impacts, lower risks to human health, residue-free fruits, and greater ecological balance (Pell et al. 2010).
The exploration of the diversity of actinobacteria present in extreme environments offers great potential in the development of new products for the biological control of pests (Duncan et al. 2014) since microorganisms isolated from these environments are likely to have developed resistance to high salinity, UV radiation, and low levels of nutrients, thus granting them the ability to survive in hostile conditions (Ortega-Morales et al. 2010). Studies of actinobacteria have been drawing increasing attention due to their potential for pest control (Vijayabharathi et al. 2014). Although actinobacteria from marine environments have revealed promising strains for the production of new chemical compounds (Hopwood 2007; Ikeda et al. 2003; Imada 2005; Crevelin et al. 2013; Hamedi et al. 2013), the majority of the Streptomyces isolated and tested for pest control are collected from terrestrial organisms or ecosystems (Qin et al. 2011; Arango et al. 2016).
In addition to its marine environments, Brazil hosts other underexplored biomes such as the Caatinga, Atlantic Forest, and Cerrado, as well as coastal environments that are home to approximately 20% of the world’s microbial diversity (Bruce et al. 2012; Pylro et al. 2014). The Caatinga is a biome located in a semi-arid region of northeastern Brazil, which boasts some unique characteristics. Recent studies have revealed the richness of this biome in terms of microbial biodiversity. The microorganisms found in this habitat may present specific mechanisms that allow them to survive in conditions of drastic temperature changes, intense solar radiation, and water stress (Mittermeier et al. 2002; Arcoverde et al. 2014).
The genus Streptomyces has been reported to be a source of biologically important enzymes, including chitinases, cellulases, and glucanases (Watanabe et al. 1999; Vijayabharathi et al. 2014; Arango et al. 2016). Enzymes such as exochitinase, endochitinase, and chitobiase can hydrolyze chitin (1: 4) -2-acetamido-2-deoxy-β-D-glucan (Vyas and Deshpande 1989), a natural polymer that is the main constituent of insects’ exoskeletons. Therefore, the production of chitinases by actinobacteria presents biological, medicinal, and agricultural applications (Dahiya et al. 2005; Briceño et al. 2015). As a result, the use of Streptomyces as bioinsecticides has been successful in the control of insects of various orders (Bream et al. 2001; Arasu et al. 2013). Its activity may be associated with the synthesis of several metabolites that constitute promising active substances for the development of new biopesticides (Box et al. 1973; Silva et al. 2014).
The present study sought to evaluate the potential of Streptomyces strains isolated from marine and caatinga biomes to control D. fovealis pests in strawberries, considering its chitinolytic activity.
Material and methods
Insect rearing
Healthy adults of D. fovealis were collected in strawberry fields and maintained in cages in the laboratory under the following controlled conditions: 25 ± 2 °C temperature, 70 ± 10% relative humidity (RH), and 14 h photoperiod. Adults were kept in plastic cages (15 × 15 × 12.5 cm) and fed on a nutritional solution consisting of 0.5 g nipagin, 0.5 g sorbic acid, 30.0 g sugar, 10 mL honey, 170 mL beer, and 500 mL distilled water. The walls of these cages were wrapped with a paper towels for egg deposition. Larvae were fed an artificial diet, which consisted of Phaseolus vulgaris seeds (65 g L−1), wheat germ (50 g L−1), textured soy protein (25 g L−1), casein (25 g L−1), beer yeast (31 g L−1), ascorbic acid (3 g L−1), sorbic acid (1.5 g L−1), methylparaben-nipagin (2.5 g L−1), vitamins (8 mL L−1), formaldehyde (3 mL L−1), tetracycline (0.14 g L−1), and agar (20 g L−1) (Zawadneak et al. 2017).
Microorganisms
Streptomyces spp. isolates were obtained from two Brazilian regions: the intertidal zone of Ilha do Mel, in the coastal region of the state of Paraná (25°20′S, 48°20′W and 25°35′S, 48°35′W) and the Caatinga biome (08°50′01.6″S and 42°33′13.3″W). Regarding the isolation of microorganisms, one sample (15 cm3 sediment) was placed in a 250-mL sterilized Erlenmeyer flask per station and was then diluted with 135 mL of distilled water. The flasks were agitated in a shaker for 10 min at 80 rpm, and the sediment was allowed to settle for 10 min. Then, 2.0 mL of the supernatant was removed, of which 1 mL was distributed onto five Petri dishes (0.2 mL per dish) containing Czapeck Dox Agar M075 medium (Himedia). The composition of ingredients in g L−1 was as follows: 30.0 g sucrose, 2.0 g sodium nitrate, 1.0 g dipotassium phosphate, 0.5 g magnesium sulfate, 0.5 g potassium chloride, 0.01 g ferrous sulfate, and 15.0 g agar, with a final pH (at 25 °C) of 7.3 ± 0.2. The remaining 1 mL was distributed in five Petri dishes (0.2 mL per dish) containing Czapeck medium (Himedia). The solution was spread on the plates with Drigaslki handles and was then incubated at 28 ± 1 °C with a 12 h photoperiod for a maximum of 7 days. Subsequently, the colonies were purified and transferred to test tubes. The strains from the marine environments are deposited at the TaxonLine Paraná State Network of Microbiological Culture Collections (CMRP, Brazil), whereas the caatinga strains are deposited at the Collection of Microorganisms of Agricultural and Environmental Importance (CCMA, EMBRAPA, Brazil).
Ovicidal and larvicidal activity of the actinobacteria isolates against Duponchelia fovealis
Egg bioassay
Eggs of 0–24 h age deposited by adult females on paper towels (20 cm × 22 cm, weight 40 g m−2) were immersed for 5 s in bacterial suspension containing 1.5 × 108 spores mL−1 (0.85% NaCl + Tween® 80); a saline solution (0.85% NaCl + Tween® 80) was used as the control. The concentration 1.5 × 108 spores mL−1 correspond to the recommended dose for field applications (Agrofit 2021). After their death, the eggs were placed in sterile Petri dishes (90 × 15 mm) containing a moist disk of filter paper (weight of 80 g m−2, porosity of 3 μm, diameter of 110 mm). The plates were kept under controlled conditions (25 ± 2 °C, RH 60 ± 10%, 12 h photoperiod). Hatching was evaluated after 7 days.
The experimental design of the egg’s bioassay was completely randomized. Five replicates, each consisting of a Petri dish with ten eggs of D. fovealis in clump, were performed for each of 51 Streptomyces spp. isolated or for the saline solution. An ANOVA with a binomial distribution test (P < 0.05) was used for analyzing the data.
Larvae bioassays
Duponchelia fovealis first-instar larvae were fed expanded leaves of organic strawberries of the ‘San Andreas’ cultivar treated with actinobacteria. For this purpose, the extremity of each leaf petiole was sanitized with sodium hypochlorite (5%) and distilled water. Then, the petioles were wrapped in moist cotton wool and placed in a glass tube (15 mL) containing bacterial suspensions with 1.5 × 108 spores mL−1 (0.85% NaCl + Tween® 80) or a saline solution (0.85% NaCl + Tween® 80) for the control. Subsequently, the leaves were conditioned into acrylic boxes (11 × 11 × 3.5 cm). The larvae of D. fovealis were then transferred to each box and kept under controlled conditions (25 ± 2 °C, RH 70 ± 10%, photoperiod 14 h). Mortality was evaluated after 4 days, and the insects that did not react to the touch of a fine bristle brush were considered dead.
The experimental design was completely randomized. Five replicates, each consisting of an acrylic box with ten D. fovealis first-instar larvae, were assembled for each of the 51 Streptomyces spp. isolated or for the saline solution. Statistical analysis consisted of ANOVA tests with a binomial distribution (P < 0.05).
Promising isolates and genetic sequence database codes of actinobacteria
Based on the bioassays of eggs and first-instar larvae of D. fovealis, promising isolates of actinobacteria that caused mortality ≥ 40% in both tests were selected to undergo further analysis. These isolates were genetically sequenced (Babu et al. 2017) and deposited in the GenBank database under the codes JX9971481 (T26), JX9971471 (T40), JX9971401 (T41), MZ021512 (T49), and MZ021510 (T50).
Detection of chitinase activity in actinobacteria strains
A modified Luria–Bertani Agar (LA) medium (Sambrook et al. 1989), without sodium chloride and with lower concentrations of peptone and yeast extract (peptone 5 g mL−1; yeast extract 3 g mL−1 and agar 13 g mL−1) and mixed with colloidal chitin at 2% (Reid and Ogrydziak 1981) was used to stimulate the expression of hydrolases. The chitin was prepared using 12.5 g of flaked chitin (SigmaC9213), ground in a blender (PH900, Philco, Brazil), and then sieved into 0.150- and 0.075-mm meshes. The retained fraction was resuspended in 125 mL of 85% H3PO4 and stored at 4 °C for 24 h. The suspension was diluted in 1 L of distilled water, homogenized in a blender, and centrifuged three times at 8000 × for 10 min. Before a fourth blending cycle, the pH was adjusted to 7.2. The LA medium with 2% colloidal chitin was poured into Petri dishes (90 × 15 mm), and after solidification, a 5-mm-diameter well was made, and 5-mm-diameter disks of actinobacteria cultured for 5 days at 28 ± 2 °C were inoculated. The actinobacteria strains able to degrade chitin formed a halo around the colonies; the halos were measured with a pachymeter (0–150 mm, Zaas Precision, Brazil).
Actinobacteria protein extract production
Actinobacteria cultures were grown in an M9 Salt Broth culture medium (33.9 g disodium phosphate, 15 g monopotassium phosphate, 2.5 g sodium chloride, and 5 g ammonium chloride in 1 L of distilled water) (Quecine et al. 2008), with 0.5% insoluble chitin meant to stimulate the production of extracellular chitinase. The spores were kept for 7 days at 30 °C with 150 rpm agitation and were then centrifuged at 10,000 g for 5 min; the supernatant was stored at 4 °C until analysis. The samples were concentrated by lyophilization using a Modulyo Freeze Dryer machine (Thermo electron Corporation, USA). The supernatant concentrations were analyzed following the Bradford method (1976). Bradford’s reagent (Bio-Rad Laboratories, Inc) was added to each plate’s wells, resulting in a final reaction of 200 μL. The reaction was incubated in the dark for 20 min and read using an ELx 800 reader (Meridian Diagnostics, Inc.) at 575 nm. The concentration of total proteins was obtained from the standard curve of bovine serum albumin (Sigma-Aldrich).
Production of actinobacteria crude extracts
The actinobacteria were inoculated in five Erlenmeyer flasks containing 50 mL of Czapeck-Dox liquid medium (30 g sucrose, 3 g sodium nitrate, 1 g dipotassium phosphate, 0.5 g magnesium sulfate, 0.5 g potassium chloride, 0.01 g ferrous sulfate, and 15 g agar in 1000 mL distilled water; pH 7.3 ± 0.2) with 20% potato broth. Growth was allowed to take its course for 4 days at 28 ± 2 °C with 150 rpm agitation. The suspensions were then transferred into five Erlenmeyer flasks containing 150 mL of the same culture medium and incubated in a shaker for 10 days at 28 ± 2 °C with 150 rpm agitation. The secondary metabolites were extracted according to instructions by Canova et al. (2010), using ethyl acetate (EtOAc) as the solvent, which was then evaporated with a rotary evaporator (R-250/B-490, Buchi, Switzerland) at 45 °C.
Anti-feeding, larvicidal, and ovicidal activity of actinobacteria extracts
The efficiency of the extracts obtained from actinobacteria was evaluated by feeding the D. fovealis first-instar larvae with strawberry leaf disks of 5 mm in diameter, which had previously been dipped for 5 s in either the chitinase extracts at 5 μg mL−1 total protein, or in the crude extract at 15 mg mL−1. The control involved dipping the leaf disks in a saline solution (0.85% NaCl + Tween® 80). This procedure was carried out over 5 days; then, regular feeding with untreated leaves was resumed for another 7 days. During the trial period, the larvae were conditioned in acrylic boxes (11 × 11 × 3.5 cm) under controlled conditions (25 ± 2 °C, 60 ± 10% RH and 12 h photoperiod). The weight and the mortality of D. fovealis larvae were tallied on the 12th day. Five replicates with ten larvae each were assembled for each treatment. An ANOVA with a binomial distribution test (P < 0.05) was used to analyze the data regarding larvae mortality.
Leaf area was measured using WinRhizo Pro™ (Regent Instruments, Inc.). In order to calculate the preference index (Kogan and Goeden 1970), the leaf area consumed throughout the different treatments was analyzed using the formula:
where PI = preference index; T = area consumed of the treated leaf disk (cm2); and C = area consumed of the control leaf disk (cm2). Treatments were considered neutral when PI was equal to 1, deterrent when PI was lesser than 1, and stimulant when PI was greater than 1.
For the activities assessing the ovicidal effects of actinobacteria, the eggs (0–24 h of age) deposited by females on paper towels (20 cm × 22 cm, weight 40 g m−2) were immersed for 5 s in the chitinase extracts at 5 μg mL−1 total protein, or in the crude extract at 15 mg mL−1 (0.85% NaCl + Tween® 80). Saline solution (0.85% NaCl + Tween® 80) was used as control. After drying, the eggs were placed in sterile Petri dishes (90 × 15 mm) containing a moist disk of filter paper (weight of 80 g m−2, porosity of 3 µm, diameter of 110 mm). The Petri dishes were kept in the same conditions applied for the larvae for 7 days. Egg viability was evaluated based on the hatching of larvae. Five replicates with ten eggs each were performed per treatment. An ANOVA with a binomial distribution test (P < 0.05) was used to analyze data regarding mortality of the eggs.
Growth inhibition of Duponchelia fovealis by actinobacteria extract
The five best-performing extracts were tested by applying 2 μL directly to the thorax of D. fovealis first-instar larvae. The control consisted of applying of 2 µL of sterilized distilled water. The insects were then placed in an acrylic box (11 × 11 × 3.5 cm) and fed strawberry leaves ad libitum in order to reach the adult larvae stage; they were kept under controlled conditions (temperature of 25 ± 2 °C, relative humidity of 70 ± 10%, and photoperiod of 14 h). The individuals were analyzed daily at the larva, pre-pupa, pupa, and adult-larva stages, where lifespan was always expressed in days. Survival (%) was assessed by counting the number of individuals alive in each stage.
The experimental design was completely randomized. Eight replicates, each consisting of one acrylic box with ten first-instar larvae, were assembled for each of the five treatments or the saline solution. An ANOVA test followed by a Tukey multiple comparison test with a significance level (P < 0.05) was used for analyzing the data.
FT-IR analysis
Duponchelia fovealis adults (from the control and the treatments with imposed development changes) that emerged from the experiments described above were then processed into powder in an agate mortar. Samples were stored at − 20 °C until they were analyzed using Fourier-transform infrared spectroscopy (FT-IR), which was carried out in triplicate. Chitin from shrimp shells (Himedia, India) was used as a reference. The spectra were recorded with a Vertex 70 FT-IR spectrometer (Bruker Optics, Ettinger, Germany) along with a steel-based DRIFT unit. All spectra were recorded from 4000 to 400 cm−1 (wavelength) with a resolution of 4 cm−1 and 64 scans. Spectra analysis was performed with Unscrambler software (version 9.7, Camo Software AS, Oslo, Norway) using a 3-point smoothing transformation and baseline correction (Cárdenas et al. 2004).
Results
Ovicidal and larvicidal activity of actinobacteria isolates on Duponchelia fovealis
Of the 51 isolates analyzed, six led to a decreased viability of the eggs (F = 16, df = 50, P < 0.05), causing a reduction in larvae hatching of up to 46%. The T23, T40, T41, T49, T50, and T26 strains caused mortality ranging between 40.4 and 46.0% (Table 1). We found significant differences in the larvae’s susceptibility levels following the ingestion test (F = 16, df = 50, P < 0.05) (Table 1). Of the strains that were tested, T50 (65.1%) and T51 (65.7%) had higher larval mortality, while the remaining strains caused mortality in under 60% of cases (Table 1). Streptomyces of the T26, T40, T41, T49, and T50 varieties were selected for the production of the extracts because they demonstrated both ovicidal and larvicidal effects in both tests ≥ 40% (Table 1).
Detection of chitinase activity and crude extract production of actinobacteria
Chitin assay degradation showed that strain T41 (halos of 17 mm in diameter), T50 (halos of 15 mm in diameter), and T40 (halos of 10 mm in diameter) were all able to produce chitinase and degrade chitin (Fig. 1), which makes them good candidates for the production of chitinase extract. In contrast, stains T26 and T49 formed halos with diameters of 7 and 3 mm, respectively.
The total protein was analyzed and the samples showed differences in their compositions, where the protein extract containing chitinase had values of 57.31 μg mL−1 (T41), 50.1 5 μg mL−1 (T50), 42.73 μg mL−1 (T49), 35.06 μg mL−1 (T40), and 11.48 μg mL−1 (T26). As for the crude extract, the amounts ranged from 0 to 24.91 μg mL−1, as follows: T41 (24.91 μg mL−1), T50 (18.01 μg mL−1), T49 (8.36 μg mL−1), T40 (3.04 μg mL−1), and T26 (0 μg mL−1).
Antifeeding activity and mortality
The T41Cr, T49Cr, and T50Cr crude extracts (Table 2) showed deterrent properties, which resulted in lower larval weights (4–7 mg). Similarly, the protein extracts containing chitinase T41Ch and T49Ch caused an anti-feeding effect where the resulting larval weight was 4 mg (Table 2).
Overall, the larvae that were fed strawberry leaves treated with T26Ch, T26Cr, T41Ch, and T41Cr for 12 days had a higher mortality rate than the other strains for both of the extracts produced (Fig. 2 A and B). Regarding the ovicidal effect, we observed that the protein extracts containing chitinase T26Ch (50% mortality) and T50Ch (37% mortality) caused decreased larval hatching (Fig. 2A). On the other hand, crude extract T26 Cr (54% mortality), T40Cr (35% mortality), and T41Cr (36% mortality) showed lower D. fovealis egg viability (Fig. 2B). Therefore, we performed the subsequent assay with samples of T26Ch, T41Cr, T40Cr, T49Cr, and T50Ch.
Mortality (mean ± standard error) of Duponchelia fovealis eggs and larvae treated with Streptomyces spp. strains T26, T40, T41, T49, and T50 after 12 days under controlled conditions (temperature of 25 ± 2 °C, relative humidity of 70 ± 10%, and photoperiod of 14 h). Note: A Protein extract containing chitinase (Ch) at 5 μg mL−1 and (B) crude extract (Cr) at 15 mg mL−1. Means followed by the same letter, lowercase (eggs) and uppercase (larvae) do not differ statistically by Tukey’s test (P < 0.05)
Growth inhibition
The extracts obtained from actinobacteria cultures behaved differently on D. fovealis with regard to survival and lifespan (Table 3). The extracts with the best results were T49Cr, with a larval-adult lifespan of 65.3 ± 0.5 days and survival of 61.2 ± 1.2%, and T26Ch, with a larval-adult lifespan of 67.5 ± 0.7 days and survival of 61.2 ± 1.2%. The adults that emerged from these two treatments were further analyzed with FT-IR.
FT-IR analysis
Figure 3 shows the FT-IR spectra of chitin obtained from commercial shrimp, as well as control and treated moths. Commercial chitin presented the main α-chitin bands (1665 and 1623 cm−1) (Fig. 3A), which, when compared to the control spectra (1662 and 1629 cm−1) (Fig. 3B), demonstrates that the chitin present in D. fovealis is in the alpha form (Fig. 3 C and D). The α-chitin bands in the control had lower intensity when compared to those of the commercial chitin. This difference is probably due to the detection of other proteins present on the moth’s body when using infrared spectroscopy. The spectra of the moths that were exposed to the extracts showed clear differences in the chitin bands (Fig. 3 C and D). The second band (1620 cm−1) was lost in both treatments. Additionally, moths treated with T49Cr presented a new band at 1740 cm−1.
The effects of crude and chitinase extracts on the chitin of adult moths were clearly observed in both the control and the treatment groups (Fig. 4). The T26Ch and T49Cr extracts exhibited macroscopic changes, including pupa deformity (Fig. 4 D and F) and anomalies on the wings (Fig. 4E) and abdomen (Fig. 4G). These defects were observed in eggs (Fig. 4A), pupas (Fig. 4B), and adults (Fig. 4C) of D. fovealis treated with saline solution.
Morphological abnormalities of Duponchelia fovealis treated with Streptomyces spp. Normal egg posture, detail of eggs in circle (A), normal pupa, arrow: normal body development (B), normal adult arrow: normal wing development (C), (D, E) abnormal development of pupa and adult treated with T49Cr (F, G) abnormal development of pupa and adult treated with T26Ch
Discussion
Our results show that the caatinga biome and the marine environment have a microbiota that shows potential as biocontrol agents and secondary metabolite producers. Research on microbial diversity in extreme environments presents great potential for the discovery of new products since such microorganisms produce unique enzymes and toxins that allow them to thrive in these environments (Duncan et al. 2014). These results indicated similarity of isolates from this study with other soil associated Streptomyces spp., which were efficient against arthroprodes (Kekuda et al. 2010; Anwar et al. 2014; Dahmana et al. 2020).
Overall, actinobacteria isolates demonstrated several deleterious effects on D. fovealis. The study of actinobacteria has been attracting attention because of its potential in biological control. Many species produce complex secondary metabolites with antibiotic and insecticidal properties (Doumbou et al. 2001; Silva et al. 2014; Rashad et al. 2015).
Aiming to find the best candidate for the control of D. fovealis, we assessed different strains and their extract’s activity through several analyses of different stages of insect development. We observed the ability of the suspended actinobacteria to circulate in the conducting vessels of the strawberry plant and affect D. fovealis. When we analyzed the plants contaminated by the bacteria, we observed that the larvae presented different susceptibility levels. Isolates from treatments T26, T40, T41, T49, and T50 were selected as they caused higher mortality rates on D. fovealis eggs and first-instar larvae. Larvae in the early stages of development are more susceptible, so the use of control methods at this stage not only prevents the development of insects but decreases their impacts on crop production (Souza et al. 2021).
We found that the chitinase extract and the crude extract obtained from the secondary metabolites of actinobacteria caused mortality to D. fovealis, with different levels of incidence in larvae and eggs. In addition, we substantiated the deterrence posed by both crude and chitinase extracts of strains T49 and T41. We observed that the presence of the extract when sprinkled to coat the leaves resulted in lower feeding rates among the larvae. The ingestion of leaves treated with the extracts may have led to the destruction of the peritrophic membrane, thus causing the larvae not to feed well and resulting in a low growth rate (Binod et al. 2007; Patil and Jadhav 2015).
Actinobacteria have been reported to be a source of important enzymes, including chitinases (Watanabe et al. 1999; Patil and Jadhav 2015; Rashad et al. 2015; Yandigeri et al. 2015). These enzymes have been receiving increased attention due to their potential in the biological control of phytopathogenic fungi and pest insects (Kramer and Muthukrishnan 1997; Law et al. 2017).
FT-IR is a well-established technique used to characterize compounds such as chitin, which was important for corroborating our results. When comparing adult moths from the control to those of the treatment, our data indicated that the crude and chitinase extracts affected chitin formation. Chitin may be found in different forms, the most common being α- and β-chitin. They can be distinguished by their FT-IR spectra: while α-chitin has two bands in the amide I region (1660 and 1627 cm−1), β-chitin has only one band at the 1656 cm−1 region (Cárdenas et al. 2004). The commercial chitin used as reference in this study presented the main bands of α-chitin and allowed us to verify that the chitin from D. fovealis is of the alpha form, as is the case with the chitin from other insects (Kaya and Baran 2015; Chandran et al. 2016; Mehranian et al. 2017). The band responsible for the vibration of 1660 cm−1 is part of the carbonyl group, bonded by hydrogen bonds to the amino group in the same chain. The other part of the carbonyl groups is bonded to hydroxymethyl groups (-CH2OH) by side chains; these bonds produce a band at 1627 cm−1 (Cárdenas et al. 2004) and are less intense. The results showed that the crude and chitinase extracts affected the α-chitin from the adult moths in different ways. The crude extract contains several different enzymes that may have degraded other moth metabolites and contributed to the different bands. Nevertheless, both treatments showed that the chitin from the adult moths was affected by the extracts.
In conclusion, our results revealed that the actinobacteria isolated from extreme environments (marine and Caatinga) were very promising in controlling D. fovealis. The extracts affected the growth of larvae when applied topically and also presented feeding deterrent properties. Actinobacteria caused mortality in larvae, and adults emerging from treatments with extracts obtained from actinobacteria presented abnormal morphologies. In the future, we intend to isolate and identify the bioactive substances. The potential observed in the Streptomyces isolates from the Caatinga and marine environments reinforces the position that these habitats should be surveyed for microorganisms producing metabolites that show promise in the development of new biopesticides.
References
Agrofit (2021) Sistemas de agrotóxicos fitossanitários. Available at: https://agrofit.agricultura.gov.br/agrofit_cons/principal_agrofit_cons. Acess on: October 27. 2021
Amatuzzi RF, Cardoso N, Poltronieri AS, Poitevin CG, Dalzoto P, Zawadeneak MA, Pimentel IC (2017) Potential of endophytic fungi as biocontrol agents of Duponchelia fovealis (Zeller) (Lepidoptera: Crambidae). Braz J Biol 78:429–435. https://doi.org/10.1590/1519-6984.166681
Amatuzzi RF, Poitevin CG, Poltronieri AS, Zawadneak MAC, Pimentel IC (2018) Susceptibility of Duponchelia fovealis Zeller (Lepidoptera: Crambidae) to soil-borne entomopathogenic fungi. Insects. 9:70. https://doi.org/10.3390/insects9020070
Anwar S, Ali B, Qamar F, Sajid I (2014) Insecticidal activity of actinomycetes isolated from salt range, Pakistan against mosquitoes and red flour beetle. Pak J Zool 46:83–92
Arango RA, Carlson CM, Currie CR, McDonald BR, Book AJ, Green F, Lebow NK, Raffa K (2016) Antimicrobial activity of actinobacteria isolated from the guts of subterranean termites. Environ Entomol 45:1415–1423. https://doi.org/10.1093/ee/nvw126
Arasu MV, Al-Dhabi NA, Saritha V, Duraipandiyan V, Muthukumar C, Kim SJ (2013) Antifeedant, larvicidal and growth inhibitory bioactivities of novel polyketide metabolite isolated from Streptomyces sp. AP-123 against Helicoverpa armigera and Spodoptera litura. BMC Microbiol 13:105
Arcoverde JHV, Carvalho AS, Neves FPA, Dionizio BP, Pontual EV, Paiva PMG, Napoleão TH, Correia MT, Silva MV, Cunha MGC (2014) Screening of Caatinga plants as sources of lectins and trypsin inhibitors. Nat Prod Res 28:1297–1301. https://doi.org/10.1080/14786419.2014.900497
Babu SA, Stien D, Eparvier V, Parrot D, Tomasi S, Suzuki MT (2017) Multiple Streptomyces species with distinct secondary metabolomes have identical 16S rRNA gene sequences. Sci Rep 7:11089. https://doi.org/10.1038/s41598-017-11363-1
Binod P, Sukumaram RK, Shirke SV, Rajput JC, Pandey A (2007) Evaluation of fungal culture filtrate containing chitinase as a biocontrol agent against Helicoverpa armigera. J Appl Microbiol 103:1845–1852. https://doi.org/10.1111/j.1365-2672.2007.03428.x
Box SJ, Cole M, Yeoman GH (1973) Prasinons A and B: potent insecticides from Streptomyces prasianus. Appl Environ Microbiol 26:699–704
Bradford M (1976) A rapid and sensitive method for the quantitation of microgram quantities of protein utilizing the principle of protein-dye binding. Anal Biochem 72:248–254. https://doi.org/10.1016/0003-2697(76)90527-3
Brambila J, Stocks I (2010) The European pepper moth, Duponchelia fovealis Zeller (Lepidoptera: Crambidae), a Mediterranean pest moth discovered in central Florida. FDACS - Division of Plant Industry. http://www.freshfromflorida.com/pi/pest_alerts/pdf/duponchelia_fovealis.pdf (Last accessed 20 Aug 2014)
Bream AS, Ghazal SA, El-Aziz ZKA, Ibrahim SY (2001) Insecticidal activity of selected actinomycetes strains against the Egyptian cotton leaf worm Spodoptera littoralis (Lepidoptera: Noctuidae). Med Fac Landbouww Univ Gent 66:503–544
Briceño G, Fuentes MS, Rubilar O, Jorquera M, Tortella G, Palma G, Amoroso MJ, Diez MC (2015) Removal of the insecticide diazinon from liquid media by free and immobilized Streptomyces sp. isolated from agricultural soil. J Basic Microbiol 55:293–302. https://doi.org/10.1002/jobm.201300576
Bruce T, Castro A, Kruger R, Thompson CC, Thompson FL (2012) Microbial diversity of Brazilian Biomes. In: Nelson KE, Jones-Nelson B (eds) Genomics applications for the developing world. Springer, Berlin, pp 217–247
Canova SP, Petta T, Reyes LF, Zucchi TD, Moraes LB, Melo IS (2010) Characterization of lipopeptides from Paenibacillus sp. (IIRAC30) suppressing Rhizoctonia solani. World J Microbiol Biotechnol 26:2241–2247. https://doi.org/10.1007/s11274-010-0412-9
Cárdenas G, Cabrera G, Taboada E, Miranda SP (2004) Chitin characterization by SEM, FTIR, XRD, and 13C cross polarization/mass angle spinning NMR. J Appl Polym Sci 93:1876–1885. https://doi.org/10.1002/app.20647
Chandran R, Williams L, Hung A, Nowlin K, LaJeunesse D (2016) SEM characterization of anatomical variation in chitin organization in insect and arthropod cuticles. Micron 82:74–85. https://doi.org/10.1016/j.micron.2015.12.010
Crevelin EJ, Canova SP, Melo IS, Zucchi DT, Silva RE, Moraes LAB (2013) Isolation and characterization of phytotoxic compounds produced by Streptomyces sp. AMC 23 from red mangrove (Rhizophora mangle). Appl Biochem Biotechnol 171:1602–1616. https://doi.org/10.1007/s12010-013-0418-5
Dahiya N, Tewari R, Tiwari RP, Hoondal GS (2005) Chitinase from Enterobacter sp. NRG4: its purification, characterization and reaction pattern. Electron J Biotechnol 8:134–145. https://doi.org/10.4067/S0717-34582005000200003
Dahmana H, Sambou M, Raoult D, Fenollar F, Mediannikov O (2020) Biological control of Aedes albopictus: obtained from the new bacterial candidates with insecticidal activity. Insects 11:403. https://doi.org/10.3390/insects11070403
Doumbou CL, Salove MKH, Crawford DL, Beaulieu C (2001) Actinomycetes, promising tools to control plant diseases and to promote plant growth. Phytoprot 82:85–102
Duncan K, Haltli B, Gill KA, Kerr RG (2014) Bioprospecting from marine sediments of New Brunswick, Canada: Exploring the relationship between total bacterial diversity and actinobacteria diversity. Mar Drugs 12:899–925. https://doi.org/10.3390/md12020899
Hamedi J, Mohammadipanah F, Ventosa A (2013) Systematic and biotechnological aspects of halophilic and halotolerant actinomycetes. Extremophiles 17:1–13. https://doi.org/10.1007/s00792-012-0493-5
Harper DR (2006) Biological control by microorganisms. In: The encyclopedia of life sciences. Wiley, Chichester. https://doi.org/10.1002/9780470015902.a0000344.pub3
Hopwood DA (2007) Therapeutic treasures from the deep. Nat Chem Biol 3:457–458. https://doi.org/10.1038/nchembio0807-457
Ikeda H, Ishikawa J, Hanamato A, Shinose M, Kikuchi H, Shiba T (2003) Complete genome sequence and comparative analysis of the industrial microorganism Streptomyces avermitilis. Nat Biotechnol 21:526–531. https://doi.org/10.1038/nbt820
Imada C (2005) Enzyme inhibitors and other bioactive compounds from marine actinomycetes. Antonie Van Leeuwenhoek 87:59–63. https://doi.org/10.1007/s10482-004-6544-x
Kaya M, Baran T (2015) Description of a new surface morphology for chitin extracted from wings of cockroach (Periplaneta americana). Int J Biol Macromol 75:7–12. https://doi.org/10.1016/j.ijbiomac.2015.01.015
Kekuda TRP, Shobha KS, Onkarappa R (2010) Potent insecticidal activity of two Streptomyces species isolated from the soils of the Western ghats of Agumbe, Karnataka. J Nat Pharm 1:30–32. https://doi.org/10.4103/2229-5119.73584
Kogan M, Goeden RD (1970) The host-plant range of Lema trilineata daturaphila (Coleoptera: Chrysomelidae). Ann Entomol Soc Am 63:1175–1180. https://doi.org/10.1093/aesa/63.4.1175
Kramer KJ, Muthukrishnan S (1997) Insect chitinases: molecular biology and potential use as biopesticides. Insect Biochem Mol Biol 27:887–900. https://doi.org/10.1016/S0965-1748(97)00078-7
Law JW, Ser HL, Khan TM, Chuah LH, Pusparajah P, Chan KG, Goh BH, Lee LH (2017) The potential of Streptomyces as biocontrol agents against the rice blast fungus, Magnaporthe oryzae (Pyricularia oryzae). Front Microbiol. https://doi.org/10.3389/fmicb.2017.00003
Matyjaszcyk E (2015) Products containing microorganisms as a tool in integrated pest management and the rules of their market placement in the European Union. Pest Manag Sci 71:1201–1206
Mehranian M, Pourabad RF, Bashir NS, Taieban S (2017) Physicochemical characterization of chitin from the Mediterranean flour moth, Ephestia kuehniella Zeller (Lepidoptera: Pyralidae). J Macromol Sci, Part A 54:720–726. https://doi.org/10.1080/10601325.2017.1332461
Mittermeier RA, Mittermeier CG, Gil PR, Pilgrim J, Fonseca GAB, Brooks T, Konstant WR (2002) Wilderness: earth’s last wild places. CEMEX Agrupación Sierra Madre, Mexico
Moshi AP, Matoju I (2017) The status of research on and application of biopesticides in Tanzania. Crop Prot 92:16–28
Ortega-Morales BO, Chan-Bacab MJ, Rosa-Garcia SC, Camacho-Chab JC (2010) Valuable processes and products from marine intertidal microbial communities. Curr Opin Biotechnol 21:346–352. https://doi.org/10.1016/j.copbio.2010.02.007
Patil SN, Jadhav JP (2015) Significance of Penicillium ochrochloron chitinase as a biocontrol agent against pest Helicoverpa armigera. Chemosphere 128:231–235. https://doi.org/10.1016/j.chemosphere.2015.01.038
Pell JK, Hannam JJ, Steinkraus JJ (2010) Conservation biological control using fungal entomopathogens. Biocontrol 55:187–198. https://doi.org/10.1007/s10526-009-9245-6
Pylro VS, Roesch LFW, Ortega JM, Amaral AM, Tótola MR, Hirsch PR, Rosado AS, Góes-Neto A, Silva ALC, Rosa CA, Morais DK, Andreote FD, Duarte GF, Melo IS, Seldin L, Lambais MR, Hungria M, Peixoto RS, Kruger RH, Tsai SM, Azevedo V (2014) Brazilian Microbiome Project: revealing the unexplored microbial diversity – challenges and prospects. Microb Ecol 67:237–241. https://doi.org/10.1007/s00248-013-0302-4
Qin S, Xing K, Jiang J, Xu L (2011) Biodiversity, bioactive natural products and biotechnological potential of plant-associated endophytic actinobacteria. Appl Microbiol Biotechnol 89:457–573. https://doi.org/10.1007/s00253-010-2923-6
Quecine MC, Araujo WL, Marcon J, Gai CS, Azevedo JL, Pizzirani-Kleiner AA (2008) Chitinolytic activity of endophytic Streptomyces and potential for biocontrol. Lett Appl Microbiol 47:486–491. https://doi.org/10.1111/j.1472-765X.2008.02428.x
Rashad FM, Fathy HM, El-Zayat AS, Elghonaimy AM (2015) Isolation and characterization of multifunctional Streptomyces species with antimicrobial, nematicidal and phytohormone activities from marine environments in Egypt. Microbiol Res 175:34–47. https://doi.org/10.1016/j.micres.2015.03.002
Reid JD, Ogrydziak DM (1981) Chitinase-overproducing mutant of Serrratia marcescens. Appl Environ Microbiol 41:664–669
Sambrook J, Fritsch EF, Maniatis T (1989) Molecular cloning: a laboratory manual. Cold Spring Harbor Laboratory Press, New York
Silva LJ, Crevelin EJ, Souza WR, Moraes LAB, Melo IS, Zucchi TD (2014) Streptomyces araujoniae produces a multiantibiotic complex with ionophoric properties to control Botrytis cinerea. Phytopathol 104:1298–1305. https://doi.org/10.1094/PHYTO-11-13-0327-R
Souza MT, Souza MT, Bernardi D, Melo DJ, Zarbin PHG, Zawadneak MAC (2021) Insecticidal and oviposition deterrent effects of essential oils of Baccharis spp. and histological assessment against Drosophila suzukii (Diptera: Drosophilidae). Sci Rep 11:3944. https://doi.org/10.1038/s41598-021-83557-7
Stocks SD, Hodges A (2011) European pepper moth or Southern European marsh pyralid Duponchelia fovealis (Zeller). Available in http://edis.ifas.ufl.edu/pdffiles/IN/IN91000.pdf (Last accessed 20 Aug 2014)
Vijayabharathi R, Kumari BR, Sathya A, Srinivas V, Abhishek R, Sharma HC, Gopalakrishnan S (2014) Biological activity of entomopathogenic actinomycetes against lepidopteran insects (Noctuidae: Lepidoptera). Can J Plant Sci 94:759–769. https://doi.org/10.1139/CJPS2013-298
Vyas P, Deshpande MV (1989) Chitinase production by Myrothecium verrucaria and its significance for fungal mycelial degradation. J Gen Appl Microbiol 35:343–350. https://doi.org/10.2323/jgam.35.343
Watanabe T, Kanai R, Kawase T, Tanabe T, Mitsutomi M, Sakuda S, Miyashita K (1999) Family 19 chitinases of Streptomyces species: characterization and distribution. Microbiology 145:3353–3363. https://doi.org/10.1099/00221287-145-12-3353
Yandigeri MS, Malviya N, Solanki MK, Shrivastava P, Sivakumar G (2015) Chitinolytic Streptomyces vinaceusdrappus S5MW2 isolated from Chilika lake, India enhances plant growth and biocontrol efficacy through chitin supplementation against Rhizoctonia solani. World J Microbiol Biotechnol 31:1217–1225. https://doi.org/10.1007/s11274-015-1870-x
Zawadneak MAC, Gonçalves RB, Pimentel IC, Schuber JM, Santos B, Poltronieri AS, Solis MA (2016) First record of Duponchelia fovealis (Lepidoptera: Crambidae) in South America. Idesia 34:91–95. https://doi.org/10.4067/S0718-34292016000300011
Zawadneak MAC, Gonçalves RB, Poltronieri AS, Santos B, Bischoff AM, Borba A, Pimentel IC (2017) Biological parameters of Duponchelia fovealis (Lepidoptera: Crambidae) reared in the laboratory on two diets. Eur. J. Entomol. 114:291–294. https://doi.org/10.14411/eje.2017.035
Acknowledgements
We are grateful to the staff of the Laboratory of Microbiology and Molecular Biology and the Laboratory of Entomology, Prof. Angelo Moreira da Costa Lima (UFPR), and Bioagro Commercial.
Funding
We thank the Brazilian Agricultural Research Corporation (EMBRAPA) and the Federal University of Paraná (UFPR) for their financial support. We would also like to thank the Brazilian Federal Agency for Support and Evaluation of Graduate Education (CAPES) and Brazilian Council for Scientific and Technological Development (CNPq) for financial support and scholarships conceived — Financing Code 001.
Author information
Authors and Affiliations
Contributions
All authors contributed to the study’s conception and design. MVP, CGP, SMT, MTS, and MTS conducted the experiments. MVP, MTS, MTS, and EDBS analyzed the data. MACZ, ICP, and ISM contributed with reagents and analytical tools. All authors wrote, read, corrected, and approved the final manuscript.
Corresponding author
Ethics declarations
Conflict of interest
The authors declare no competing interests.
Ethics approval
Not applicable.
Consent to participate
The authors declare that they consent to participate of this article.
Consent for publication
The authors declare that they consent this article for publication.
Additional information
Edited by Marcos R de Faria
Publisher's note
Springer Nature remains neutral with regard to jurisdictional claims in published maps and institutional affiliations.
Rights and permissions
About this article
Cite this article
Porsani, M.V., Poitevin, C.G., Tralamazza, S.M. et al. Streptomyces spp. Isolated from Marine and Caatinga Biomes in Brazil for the Biological Control of Duponchelia fovealis. Neotrop Entomol 51, 299–310 (2022). https://doi.org/10.1007/s13744-022-00942-1
Received:
Accepted:
Published:
Issue Date:
DOI: https://doi.org/10.1007/s13744-022-00942-1